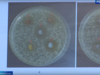
Благородный металл по мнению молодого ивановского ученого поможет бороться с рядом бактерий

ГОРЯЧАЯ ЛИНИЯ Коммунальные проблемы? Сообщите о них! Номер автоответчика: 8 (4932) 930-930
01.07.2026 20:13В ивановскую «Энергию» перешла баскетболистка из сильнейшей команды России
01.07.2026 19:43С начала года в Ивановской области введено почти 234 тысячи квадратных метров жилья
01.07.2026 19:20В четырех селах Приволжского и Родниковского районов завершают строить сети водоснабжения
01.07.2026 19:12Житель Иванова предстанет перед судом по обвинению в покушении на убийство
01.07.2026 18:51В Ивановской области простились с жителями региона – участниками спецоперации